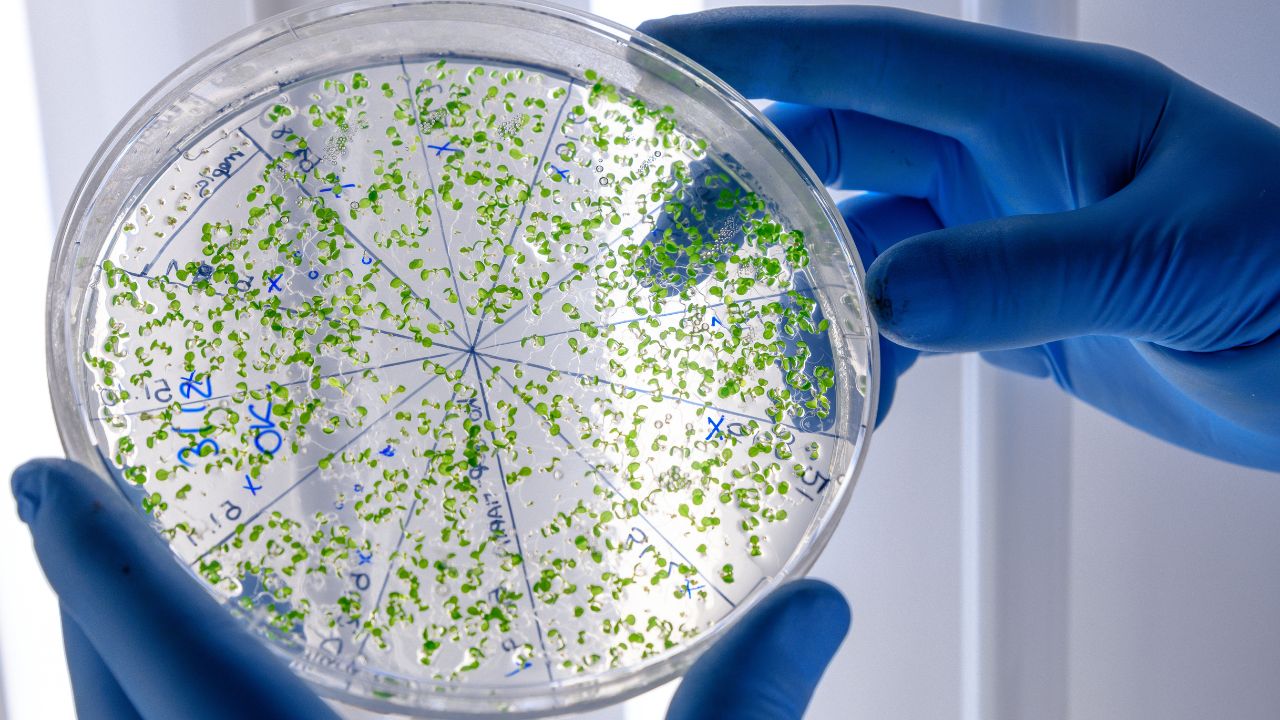
o que é exame parasitologico

Quando alguém pergunta o que é exame parasitológico, geralmente quer entender se esse teste serve para detectar vermes, protozoários, infecção intestinal ou algum tipo de alteração causada por parasitas. A resposta mais correta é que exame parasitológico é um exame laboratorial voltado à pesquisa de parasitas ou de estruturas relacionadas a eles em materiais biológicos, especialmente fezes, mas não apenas nelas.
No uso mais comum do dia a dia, a expressão costuma se referir ao exame parasitológico de fezes, que investiga parasitas intestinais e suas formas evolutivas. Mesmo assim, o conceito é mais amplo. Dependendo da suspeita clínica, o exame parasitológico pode envolver análise de diferentes materiais e técnicas variadas.
Esse tema é importante porque muita gente reduz o exame parasitológico a uma ideia muito simples, como “ver se tem verme”, quando na prática ele envolve investigação de diferentes agentes, uso de técnicas específicas, escolha correta da amostra e interpretação clínica cuidadosa.
Na prática clínica, esse exame costuma ser pedido quando há sintomas como diarreia persistente, dor abdominal, muco ou sangue nas fezes, gases, náuseas, perda de peso ou contexto de exposição a água e alimentos contaminados. Ele também pode ser solicitado quando o médico quer investigar causas infecciosas de um quadro intestinal ou acompanhar resposta ao tratamento de algumas parasitoses.
Ao longo deste conteúdo, você vai entender o que é exame parasitológico, para que serve, quais são seus tipos mais comuns, quando ele costuma ser solicitado, como funciona a coleta, o que significa um resultado positivo ou negativo e quais são as limitações mais importantes desse tipo de investigação:
O que é exame parasitológico?
Exame parasitológico é um exame laboratorial destinado a identificar parasitas ou estruturas produzidas por eles em materiais coletados do paciente. Em termos simples, ele busca sinais de infecção parasitária por meio da análise de amostras biológicas.
Quando se fala nisso no cotidiano, o foco quase sempre é o material fecal, porque muitas parasitoses intestinais eliminam formas detectáveis nas fezes. Mas o conceito não se limita a isso. O exame pode variar conforme o material analisado e conforme a hipótese clínica.
Na prática, o exame parasitológico tenta responder uma pergunta simples, mas muito importante: existe evidência laboratorial de parasita no organismo ou de estruturas relacionadas à sua presença? A resposta pode ajudar a confirmar uma suspeita clínica, orientar tratamento ou afastar parte das hipóteses investigadas.
Esse ponto é importante porque mostra que o exame parasitológico não é apenas uma curiosidade laboratorial. Ele faz parte do raciocínio diagnóstico e do cuidado em saúde.
Para que serve o exame parasitológico?
O exame parasitológico serve para investigar doenças causadas por parasitas. Isso inclui, principalmente, as parasitoses intestinais, mas em sentido mais amplo também pode envolver outros tipos de infecção parasitária, dependendo da amostra e do método utilizado.
No caso mais frequente, o exame ajuda a esclarecer se sintomas digestivos podem estar ligados à presença de parasitas no intestino. Ele costuma ser útil quando o paciente apresenta diarreia persistente, dor abdominal, fezes com sangue ou muco, náuseas, emagrecimento, fezes oleosas ou desconforto intestinal prolongado.
Também pode ser importante quando há história de ingestão de água não tratada, contato com ambientes contaminados, viagem para áreas com maior risco de parasitoses ou convivência em locais com saneamento inadequado.
Além do diagnóstico inicial, o exame também pode ser usado em algumas situações para verificar se o tratamento funcionou. Ou seja, ele não serve apenas para descobrir a infecção, mas pode, em alguns casos, participar do acompanhamento.
O exame parasitológico é sempre exame de fezes?
Não. Embora o exame parasitológico de fezes seja o mais conhecido, o termo “exame parasitológico” pode abranger outras investigações, conforme o parasita suspeito.
Na prática, isso significa que algumas doenças parasitárias são investigadas principalmente nas fezes, enquanto outras dependem de sangue ou de outros materiais. Por isso, quando alguém fala apenas “fiz exame parasitológico”, o sentido completo depende do contexto clínico e do material coletado.
Ainda assim, no uso cotidiano e em muitas buscas na internet, a expressão costuma ser empregada como sinônimo de exame parasitológico de fezes. É justamente esse o formato mais lembrado pela população porque várias parasitoses intestinais eliminam ovos, cistos ou larvas no material fecal.
O que o exame parasitológico de fezes detecta?
No caso do exame fecal, o laboratório pode detectar diferentes formas parasitárias, como ovos de helmintos, cistos de protozoários, trofozoítos, oocistos e larvas.
Isso significa que o exame não procura apenas “vermes inteiros”. Muitas vezes, o que é identificado são formas microscópicas do parasita ou estruturas relacionadas ao seu ciclo de vida. É por isso que o exame depende de técnica laboratorial adequada e de experiência na leitura.
Na prática, o resultado pode apontar diretamente o agente suspeito ou, ao menos, indicar uma forma biológica compatível com determinada parasitose. Isso ajuda o médico a definir a próxima etapa da investigação ou do tratamento.
Quando o médico costuma solicitar um exame parasitológico?
O pedido costuma acontecer quando há sintomas ou contexto compatíveis com infecção parasitária.
No caso intestinal, isso inclui diarreia, dor abdominal, muco ou sangue nas fezes, náuseas, emagrecimento e outros sinais digestivos persistentes. A investigação também ganha força quando existe exposição de risco, como água não tratada, ambientes contaminados ou viagens para áreas onde determinadas parasitoses são mais frequentes.
Em alguns cenários, o exame pode ser pedido porque o médico quer diferenciar causas possíveis de diarreia. Nem toda alteração intestinal é causada por parasita, então o exame entra como parte da investigação.
Na prática, isso quer dizer que o exame não deve ser visto como um teste aleatório. Ele ganha valor quando existe suspeita clínica razoável e quando a pergunta diagnóstica faz sentido para o quadro apresentado pelo paciente.
Como funciona o exame parasitológico na prática?
No caso mais comum, o paciente recebe um frasco e orientações de coleta. Depois de colher a amostra corretamente, o material é enviado ao laboratório, onde pode passar por etapas de conservação, concentração, preparo, coloração e exame microscópico.
Dependendo do contexto, o laboratório também pode usar testes complementares, como pesquisa de antígenos ou métodos moleculares.
Esse detalhe importa porque muita gente imagina que o exame consiste apenas em “olhar as fezes”. Na prática, a amostra pode ser examinada fresca ou preservada, e o processamento pode aumentar a chance de encontrar organismos quando estão em pequena quantidade.
Em termos simples, o exame parasitológico é tecnicamente mais elaborado do que parece. E isso ajuda a entender por que a qualidade da coleta, o transporte e o método escolhido influenciam tanto no resultado final.
O exame parasitológico de fezes precisa de preparo?
Em geral, não há necessidade de jejum. Na maioria dos casos, o exame não exige preparo alimentar especial.
Mesmo assim, existem cuidados essenciais. O principal deles é a coleta correta, sem contaminação por urina, água do vaso, papel higiênico, terra ou outros materiais.
Na prática, isso quer dizer que o mais importante não é dieta ou jejum, e sim a forma como a amostra é obtida. Uma coleta errada pode comprometer bastante o valor do exame, mesmo quando o laboratório é bom e o método é adequado.
Como fazer a coleta corretamente?
A amostra deve ser colhida em recipiente limpo, seco e bem fechado, sem contato com urina ou água.
O ideal é não evacuar diretamente na água do vaso para depois tentar retirar o material. O melhor caminho é usar um coletor apropriado, um recipiente limpo ou uma adaptação indicada pelo laboratório.
Se houver sangue, muco ou pus visíveis, essas partes devem ser incluídas na amostra, porque podem ter importância para a análise. Também é importante fechar bem o frasco, identificar quando necessário e seguir o tempo e a forma de envio orientados pelo laboratório.
Na prática, a coleta correta é uma das etapas mais decisivas do exame. Muitas falhas diagnósticas começam antes mesmo de o material chegar ao microscópio.
Quantas amostras podem ser necessárias?
Em muitos casos, mais de uma. Pode ser necessário coletar várias amostras em dias diferentes porque os parasitas podem não aparecer nas fezes todos os dias.
Isso acontece porque a eliminação de ovos, cistos e outras formas parasitárias pode ser intermitente. Ou seja, uma pessoa pode ter a infecção e, ainda assim, uma amostra isolada não conter quantidade suficiente para detecção naquele dia.
Na prática, isso ajuda a explicar por que um médico pode pedir duas ou três coletas em dias diferentes. Não é excesso de cuidado sem motivo. É uma forma de aumentar a sensibilidade do exame e reduzir o risco de falso negativo.
O que significa resultado negativo?
Um resultado negativo significa que não foram encontrados parasitas ou estruturas parasitárias na amostra analisada. Mas isso não exclui automaticamente todas as parasitoses.
Isso acontece porque um resultado negativo pode significar ausência de parasitas ou apenas ausência de quantidade suficiente deles na amostra para aparecer no exame.
Esse ponto é muito importante. Se a suspeita clínica continuar alta, o médico pode repetir a coleta ou solicitar exames complementares.
Em outras palavras, o exame negativo tem valor, mas seu peso depende do número de amostras coletadas, da qualidade do material, do método utilizado e da hipótese diagnóstica.
O que significa resultado positivo?
Um resultado positivo significa que o exame encontrou parasitas ou estruturas parasitárias na amostra. O laudo também pode trazer o tipo de parasita identificado e, em alguns casos, informações adicionais sobre a quantidade observada.
Esse resultado geralmente orienta a próxima etapa do cuidado. O tratamento vai depender do organismo encontrado, dos sintomas, da idade do paciente, do quadro clínico e da avaliação médica.
Em alguns cenários, o resultado praticamente fecha o diagnóstico. Em outros, ele precisa ser interpretado junto com a história clínica e outros exames.
Na prática, um positivo não deve ser entendido apenas como “tem verme”. O significado clínico depende do agente identificado e da situação em que ele foi encontrado.
O exame parasitológico detecta todas as parasitoses?
Não. Ele é muito útil para várias parasitoses intestinais, mas não para todas as doenças parasitárias.
Diferentes parasitas exigem estratégias diferentes de investigação. Algumas doenças são melhor investigadas por sangue, soro, tecido ou outros materiais. Em alguns casos, testes de antígeno ou métodos moleculares podem complementar ou até ser mais adequados do que a microscopia tradicional.
Na prática, isso significa que o exame parasitológico é muito importante, mas não universal. O melhor teste depende sempre da pergunta clínica feita pelo médico.
Qual é a diferença entre exame parasitológico e cultura de fezes?
O exame parasitológico pesquisa parasitas. Já a cultura de fezes é voltada principalmente para a pesquisa de bactérias intestinais.
Isso é importante porque muita gente fala “fiz exame de fezes” sem perceber que existem exames fecais diferentes. O médico escolhe o teste conforme a hipótese clínica.
Se suspeita de parasitose, tende a pedir parasitológico. Se suspeita de causa bacteriana, pode pedir cultura. Em alguns casos, os dois exames podem ser úteis ao mesmo tempo.
O exame parasitológico é um exame laboratorial destinado à pesquisa de parasitas ou de estruturas ligadas a eles em materiais biológicos, especialmente nas fezes. No uso mais comum, ele se refere ao exame parasitológico de fezes, que ajuda a investigar parasitoses intestinais e a esclarecer sintomas como diarreia, dor abdominal, muco nas fezes, emagrecimento e outros desconfortos digestivos.
Ao longo deste conteúdo, ficou claro que o exame não costuma exigir jejum, mas depende muito de coleta correta, sem contaminação com urina ou água, e que muitas vezes mais de uma amostra pode ser necessária. Também ficou evidente que um resultado negativo não exclui automaticamente todas as parasitoses e que nem toda doença parasitária é melhor investigada por fezes.
Em outras palavras, o exame parasitológico parece simples, mas seu valor real depende de técnica, contexto clínico e interpretação adequada.
Perguntas frequentes sobre o que é exame parasitológico
O que é exame parasitológico?
É um exame laboratorial feito para pesquisar parasitas ou estruturas ligadas a eles em materiais biológicos. No uso mais comum, a expressão se refere ao exame parasitológico de fezes, usado para investigar parasitas intestinais.
Exame parasitológico é a mesma coisa que exame de fezes?
Nem sempre. O exame parasitológico pode envolver diferentes materiais biológicos, mas no dia a dia a expressão costuma ser usada como sinônimo de exame parasitológico de fezes.
Para que serve o exame parasitológico?
Ele serve para investigar infecções causadas por parasitas. No caso intestinal, ajuda a esclarecer quadros como diarreia persistente, dor abdominal, muco nas fezes, perda de peso e outros sintomas digestivos.
O exame parasitológico de fezes detecta vermes?
Sim, pode detectar ovos e outras estruturas relacionadas a helmintos, além de formas de protozoários intestinais.
O exame precisa de jejum?
Em geral, não. O mais importante costuma ser a coleta correta da amostra, sem contaminação.
Posso colher a amostra direto do vaso sanitário?
O ideal é não. A amostra deve ser coletada em recipiente limpo, seco e sem contato com urina, água ou outros materiais.
Quantas amostras podem ser necessárias?
Pode ser necessário colher mais de uma amostra em dias diferentes, porque os parasitas podem não aparecer nas fezes todos os dias.
Resultado negativo significa que não tenho parasita?
Não necessariamente. Um resultado negativo pode significar ausência de parasitas ou apenas ausência de quantidade suficiente deles na amostra analisada.
Resultado positivo significa o quê?
Significa que o exame encontrou parasitas ou estruturas parasitárias na amostra. O laudo pode informar qual organismo foi identificado e orientar a conduta médica.
O exame detecta todas as doenças parasitárias?
Não. Algumas doenças parasitárias exigem sangue, soro, tecido ou métodos complementares, e não apenas fezes.
Qual é a diferença entre exame parasitológico e cultura de fezes?
O exame parasitológico procura parasitas. A cultura de fezes procura principalmente bactérias intestinais. São exames diferentes e, em alguns casos, complementares.
Quando vale a pena repetir o exame?
Quando a suspeita clínica continua alta apesar de um primeiro resultado negativo, quando a coleta inicial não foi ideal ou quando o protocolo já prevê múltiplas amostras para aumentar a sensibilidade.
Deixe um comentário